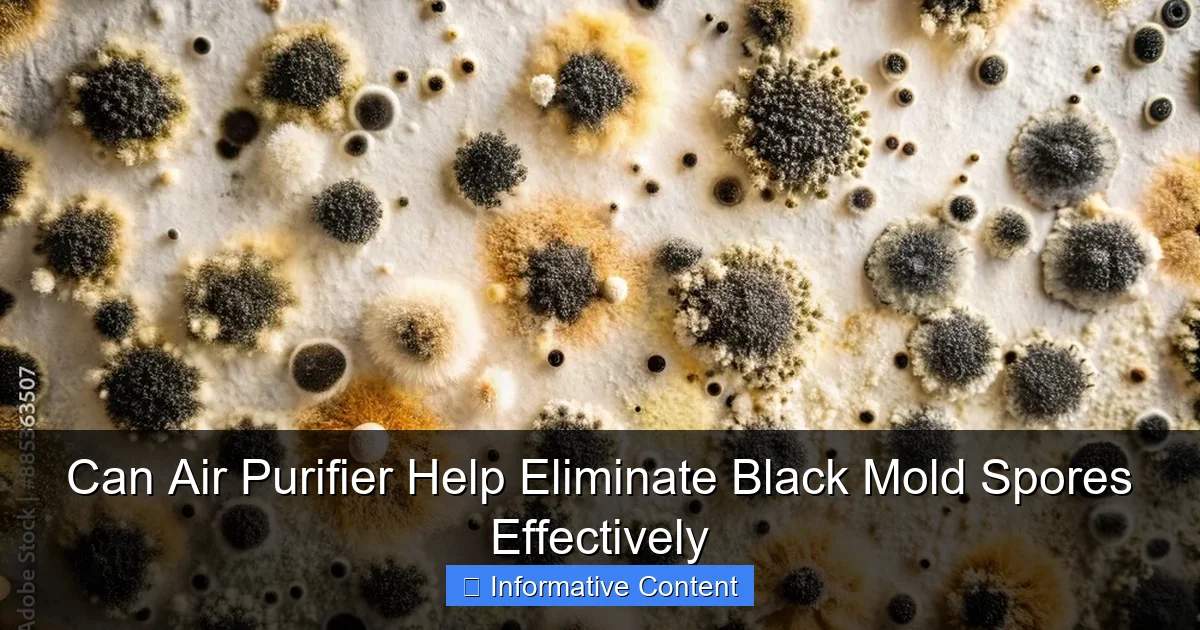
Can Air Purifier Help Eliminate Black Mold Spores Effectively

Can Air Purifier Help With Cough Discover the Truth Here
December 22, 2025
Can air purifier help with cough? Discover how air purifiers reduce allergens and irritants to ease coughing and improve respiratory health effectively

Can Air Purifier Help with Coronavirus Effectively
December 22, 2025
Discover how an air purifier can help with coronavirus by capturing airborne particles and improving indoor air quality effectively.

Can Air Purifier Help With Corona Virus Find Out Now
December 22, 2025
Discover how an air purifier can help with corona virus by reducing airborne particles Learn the science and best models for cleaner safer indoor air

Can Air Purifier Help with Cat Allergies Discover the Truth
December 22, 2025
Can air purifier help with cat allergies? Discover how air purifiers reduce allergens, improve indoor air quality, and ease allergy symptoms effectively.

Can Air Purifier Help With Carbon Monoxide What You Need to Know
December 22, 2025
Can air purifier help with carbon monoxide? Discover how air purifiers work against CO, key features to look for, and essential safety tips for your home

Can Air Purifier Help With Asthma A Complete Guide
December 22, 2025
Discover how an air purifier can help with asthma by reducing allergens and improving air quality for better breathing and fewer symptoms

Can Air Purifier Help with Asbestos A Complete Guide
December 22, 2025
Discover how an air purifier can help with asbestos removal and improve indoor air quality Learn key features to choose the right one for safety

Can Air Purifier Help with Allergies Find Out Now
December 22, 2025
Discover how an air purifier can help with allergies by reducing airborne irritants like pollen dust and pet dander for cleaner healthier air

Can Air Purifier Help My Flowers Bloom Better
December 22, 2025
Discover how an air purifier can help your flowers thrive by improving air quality reducing pollutants and creating optimal conditions for vibrant blooms nat…
Can Air Purifier Help Eliminate Black Mold Spores Effectively
December 22, 2025
Can air purifier help eliminate black mold spores effectively? Discover how HEPA filters and advanced tech combat mold spores for cleaner indoor air quality
Basics

What Air Purifier Is Best for Mold Top Picks Reviewed
December 19, 2025
Discover the best air purifier for mold with our top picks reviewed. Learn key features, performance, and expert recommendations for cleaner, healthier air.

What Air Purifier Is Best for Dust Top Picks Revealed
December 19, 2025
Discover the top air purifiers for dust removal in 2024. Find out what air purifier is best for dust and breathe cleaner air today with our expert picks

What Air Purifier Is Best for COVID 19 Protection in 2024
December 19, 2025
Discover the best air purifier for COVID 19 protection in 2024. Expert-tested models with HEPA filters to reduce airborne viruses and improve indoor air qual…

What Air Purifier Is Best for Cigarette Smoke in 2024
December 19, 2025
Discover the best air purifier for cigarette smoke in 2024. Expert-tested models to eliminate odors and harmful particles effectively for cleaner air

What Air Purifier Is Best for Asbestos Removal in 2024
December 19, 2025
Discover the best air purifier for asbestos removal in 2024. Learn key features to consider when choosing what air purifier is best for asbestos safety and e…

What Air Purifier Is Best for Allergies Top Picks Revealed
December 19, 2025
Discover what air purifier is best for allergies with our expert top picks for clean air relief from pollen dust and pet dander year round

What Air Purifier Is Best for Your Home in 2024
December 19, 2025
Discover what air purifier is best for your home in 2024 with expert reviews top picks and key features to improve indoor air quality effectively

What Air Purifier Has Biggest Carbon Filter for Maximum Freshness
December 19, 2025
Discover which air purifier has the biggest carbon filter for superior odor removal and maximum freshness in large spaces with heavy pollutants

What Air Purifier Handles Pet Dander Best for Cleaner Air
December 19, 2025
Discover what air purifier handles pet dander best for cleaner air. Expert reviews reveal top models that effectively trap allergens and keep your home fresh
Knowledgebase

Do Air Purifiers Help With Pet Allergies Reddit Users Reveal Truth
February 3, 2026
Do air purifiers help with pet allergies? Reddit users share real-life experiences and insights on effectiveness, filters, and top-rated models.

Do Air Purifiers Help with Pet Allergies Find Out Now
February 3, 2026
Discover if air purifiers help with pet allergies by reducing dander and odors for cleaner air and easier breathing in homes with pets

Do Air Purifiers Help with Paint Smell Find Out Now
February 3, 2026
Discover if air purifiers help with paint smell effectively Learn how HEPA filters and activated carbon reduce odors for fresh indoor air

Do Air Purifiers Help With Paint Fumes A Complete Guide
February 3, 2026
Do air purifiers help with paint fumes? Discover how air purifiers reduce VOCs, odors, and toxins for cleaner, safer indoor air after painting.

Do Air Purifiers Help with Ozone What You Need to Know
February 3, 2026
Do air purifiers help with ozone? Learn how different models affect ozone levels and what to consider for cleaner, safer indoor air.

Do air purifiers help with off gassing and improve indoor air quality
February 3, 2026
Do air purifiers help with off gassing? Discover how they reduce VOCs and improve indoor air quality for a healthier home environment effectively

Do Air Purifiers Help with Odors Find Out Here
February 3, 2026
Discover if air purifiers help with odors effectively Learn how they eliminate smells from pets cooking smoke and more for fresher indoor air quality

Do Air Purifiers Help with Odor and Improve Air Quality
February 2, 2026
Discover how air purifiers help with odor and enhance indoor air quality by removing pollutants, allergens, and unpleasant smells effectively.

Do Air Purifiers Help with Nose Bleeds Find Out Now
February 2, 2026
Discover if air purifiers help with nose bleeds by reducing irritants and improving air quality for healthier nasal passages and fewer episodes

Do Air Purifiers Help with Resin Fumes A Complete Guide
February 2, 2026
Do air purifiers help with resin fumes? Discover how effective air purifiers are at reducing harmful resin fumes and improving indoor air quality.
Maintenance
No results found.

